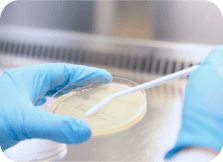

Quality and Care for Every Moment




At Sanipak, our story is woven into the fabric of daily life. Each of our brands is crafted to meet the diverse needs of families, individuals, and our planet. Through groundbreaking products and the distribution of leading brands, we enrich every moment with unparalleled quality and care, enhancing lives across generations and geographies.